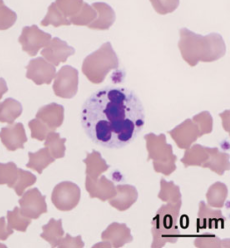

Histologic section of the inguinal lymph node. Dx? Describe.

Dx: B-cell lymphoma with plasmacytoid differentiation
(A) Note the effacement of normal architecture.
(B) The lymphocyte population has a bimorphic appearance and contains a high number of mitotic figures (arrows). The inclusions seen in the cytologic specimen are poorly visible.
B-cell lymphoma with plasmacytoid differentiation, atypical cytoplasmic inclusions, and secondary leukemia in a dog. Vet Clin Pathol 42/1 (2013) 40–46.
Cytochemical and immunochemical staining of histologic (A, B) and cytologic (C) specimens of inguinal lymph node of a dog with B-cell lymphoma with plasmacytoid differentiation. What is the staining characteristics?

(A) The inclusions are distinctly positive (bright pink) with periodic acid-Schiff, indicating carbohydrate content.
(B) Positive nuclear staining for MUM-1 is seen in both large and small lymphocytes. MUM-1 immunostain with 3-amino-9-ethylcarbazole (AEC) chromogen.
(C) Intense diffuse cytoplasmic IgM staining is observed within both large and small lymphocytes. Abundant background staining indicates large amounts of extracellular IgM. IgM immunostain
B-cell lymphoma with plasmacytoid differentiation, atypical cytoplasmic inclusions, and secondary leukemia in a dog. Vet Clin Pathol 42/1 (2013) 40–46.
Fine-needle aspirate of a mesenteric lymph node from a dog. Dx? Describe.

Dx: Mesocestoides tetrathyridium infection
Hundreds of clear, refractile, calcareous corpuscles (arrows) from a ruptured cestode larva.
Cestode infection in 2 dogs: cytologic findings in liver and a mesenteric lymph node. Vet Clin Pathol 42/1 (2013) 103–108.
Fine-needle aspirate of liver from a dog. Dx? Describe.

A Mesocestoides tetrathyridium with 4 visible round suckers (arrows).
Cestode infection in 2 dogs: cytologic findings in liver and a mesenteric lymph node. Vet Clin Pathol 42/1 (2013) 103–108.
Direct smear from tracheal wash in a dog. What are the structures?

diatoms
The presence of diatom algae in a tracheal wash from a German Wirehaired Pointer with aspiration pneumonia. Vet Clin Pathol 42/2 (2013) 221–226.
Endotracheal wash from a dog. Dx? What stain is this?

Dx: Mixed inflammation with intra- and extracellular lipid accumulation, compatible with lipid pneumonia.
Oil Red O stain reveals accumulation of lipid, both free within the background, and within the cytoplasm of a macrophage.
What is your diagnosis? An endotracheal wash from a dyspneic 3-month-old female Labrador Retriever. Vet Clin Pathol 42/4 (2013) 527–528.
Histo from an abdominal mass arising from a kidney of a dog. Dx? Describe. What is the stain in B? What are the important structures in D?

Renal carcinoma in a dog.
(A) Neoplastic renal tubules are surrounded by a thick, eosinophilic basement membrane and contain eosinophilic material within their lumina. H&E.
(B) Laminin immunostain. Light brown staining of the globules indi- cates positive immunoreactivity. 3,3′-diaminobenzidine tetrahydrochlo- ride chromogen. (C) and
(D) Transmission electron microscopy images of hyaline globules in renal carcinoma in a dog. Laminated accumulations of basement membrane are seen surrounding neoplastic renal tubules (asterisk) and within tubular lumens (boxed).
What is your diagnosis? Intracranial mass in a dog. Vet Clin Pathol 42/3 (2013) 389–390.
Peripheral blood smears made one day (Dog 1, A, B, and Dog 2, C, D), 4 days (Dog 3, E, F), 3 days (Dog 4, G, H), and 5 days (Dog 5, I, J) after vincristine administration. Describe the changes.

(A) Two polychromatophils contain several atypical nuclear remnants (Howell-Jolly bodies).
(B) A polychromatophilic RBC contains 2 nuclear bodies of unequal sizes and with undulated margins.
(C) Asynchronous maturation of the nucleus and cytoplasm in a nucleated RBC.
(D) A polychromatophilic RBC with 4 variably sized Howell-Jolly bodies.
(E) A rubricyte either with 2 nuclei of unequal sizes, or one nucleus with an abnormal nuclear bleb.
(F) An RBC with an abnormally large nuclear remnant adjacent to a smaller nuclear remnant (Howell-Jolly body) or an abnormal bleb.
(G) A metarubricyte has extruded its nucleus (on the left) and another one is in the process of extruding its nucleus (on the right).
(H) A polychromatophilic RBC has a diameter smaller than the mature RBC adjacent to it.
(I) A metarubricyte has a cerebriform nucleus. (J) An atypical erythroid mitotic figure with lagging chromosomes is present.
Erythrocyte dysplasia in peripheral blood smears from 5 thrombocytopenic dogs treated with vincristine sulfate. Vet Clin Pathol 42/4 (2013) 458–464
Histologic appearance of scapular mass in a hamster. Dx? Describe.

Dx: extraskeletal OSA
(A) Malignant mesenchymal neoplasm with both myxoid and compact areas, comprised of spindloid, hyperchromatic cells
(B) Presence of small amounts of extracellular material admixed within the compact areas
What is your diagnosis? Scapular mass in a Chinese hamster. Vet Clin Pathol 42/4 (2013) 533–534.
Histologic section from a submandibular fluid-filled mass in a horse. Dx? What are the cells + for? Describe.

Dx: Reactive lymphoid cell population, consistent with lymph fluid from an obstructed duct.
PROX-1 staining of the nuclei of lymphatic endothelium lining the channels of the mass (arrow), while normal vascular endothelium fails to stain.
What is your diagnosis? Fluid surrounding a submandibular mass from a horse. Vet Clin Pathol 42/4 (2013) 531–532.
Histologic sections of affected intestinal epithelium from a dog with peritonitis after enterotomy for foreign body removal. Dx? Describe.

Candida peritonitis
Serosa (*) is markedly thickened by infiltration of a mixed population of inflammatory cells, including neutrophils, macrophages, lymphocytes, and plasma cells. H&E, bar = 1 mm. Insets: The left inset is a magnified area of inflammation taken from the box in the serosa. H&E. The right inset highlights numerous Candida yeast and pseudohyphae from the box in the serosa. Gomori’s Methamine Silver stain.
Candida peritonitis in dogs: Report of 5 cases. Vet Clin Pathol 42/2 (2013) 227–233.
Imprints of a cystic lesion closely associated with the choroid plexus within the fourth ventricle of a dog. Dx?

Dx: Epidermoid cyst
What is your diagnosis? Cystic mass in the fourth ventricle of the brain of a dog. Vet Clin Pathol 42/3 (2013) 387–388.
Histologic section of a mammary mass of a dog. Dx? Describe. What is the arrow pointing to?

Pyogranulomatous mastitis characterized by an infiltration of mammary gland tissue by numerous macrophages, leaving few remnants of normal glandular tissue (arrowhead). Dx: Mycobacterium kansasii
Mastitis caused by Mycobacterium kansasii infection in a dog. Vet Clin Pathol 42/3 (2013) 377–381.
Serum protein electrophoresis in a cat. Describe. Dx?

Dx: multiple myeloma
monoclonal gammopathy
Left to right, fractions are albumin (29.68%, 3.44 g/dL; reference interval [RI] 2.1–3.3 g/dL), alpha 1 globulins (3.88%, 0.45 g/dL; RI 0.2–1.1 g/dL), alpha 2 globulins (13.11%, 1.52 g/dL; RI 0.4–0.9 g/dL), beta globulins (9.92%, 1.15 g/dL; RI 0.9–1.9 g/dL), and gamma globulins (43.40%, 5.03 g/dL; RI 1.7–4.4 g/dL).
Total protein was 11.59 g/dL (RI 5.4–7.8 g/dL), and A/G ratio was 0.42 (RI 0.45–1.19).
Hemophagocytic syndrome in a cat with multiple myeloma. Vet Clin Pathol 42/1 (2013) 55–60.
Cytocentrifuged preparation of BAL (upper) and CSF (lower) in a dog. Dx? Describe.

Dx: Disseminated angiostrongylosis
Angiostrongylus vasorum LI larvae have a characteristic cephalic button (short arrow) and a sinuous and sharp tail with an indented subterminal dorsal spine (long thin arrow). (Lower) Cerebrospinal fluid in a Nageotte counting chamber. Turk’s solution
What is your diagnosis? Bronchoalveolar lavage and cerebrospinal fluid from a dog in Italy. Vet Clin Pathol 42/1 (2013) 109–110.
FNA of a mammary mass in a dog. Dx? Describe the arrangements.

Dx: canine mammary micropapillary carcinoma revealing different architectural patterns.
(A) and (B)- Small papillary arrangements without fibrovascular cores.
(C) A morula-like cluster of epithelial cells.
Clinical, cytologic, and histologic features of a mammary micropapillary carcinoma in a dog. Vet Clin Pathol 42/3 (2013) 382–385.
Fecal smear from a Mallard duckling. Dx?

Dx: Coccidiosis
What is your diagnosis? Fecal smear from a Mallard duck (Anas platyrhynchos). Vet Clin Pathol 42/1 (2013) 111–112.
Cytochemistry on blood smears from a turtle with lymphoid leukemia. Which stains was this tumor + for?

Cytochemistry on blood smears, 9100 objective (A–D); and immunohistochemistry on kidney sections, 910 objective (E–F), from a turtle with lymphoid leukemia.
The neoplastic cells were positive for CD3 and some were positive for ANBE.
Heterophils positive for SBB and ALP.
Erythrocytes often have a single focal area of positive staining with ANBE and SBB.
(A) Alpha naphthyl butyrate esterase (ANBE); (B) Sudan black B (SBB); (C) Chloroacetate esterase (CAE); (D) Alkaline phospha- tase (ALP); (E) CD-3; (F) Pax-5.
Chinese Box turtle (Cuora flavomarginata) with lymphoid leukemia characterized by immunohistochemical and cytochemical phenotyping. Vet Clin Pathol 42/3 (2013) 368–376.
Neutrophil with cytoplasmic inclusions in a blood smear from a cat. Dx?
Phagocytized mast cell granules
What is your diagnosis? Blood smear from a cat. Vet Clin Pathol 42/3 (2013) 393–394.
Histologic section of an intraoperative cerebral mass biopsy from a dog. Dx? Describe. What is the stain in the second picture?

Dx: Granular cell tumor, PAS
What is your diagnosis? Impression smears of a cerebral mass from a dog. Vet Clin Pathol 42/2 (2013) 240–241.
Histologic sections of small intestine from a Mallard duckling. Dx? Describe the structures in each pic.

Dx: coccidiosis.
(A) Multiple enterocytes contain a single schizont with multiple merozoites
(B) Sloughed epithelial cells within the intestinal lumen contain unsporulated oocysts
What is your diagnosis? Fecal smear from a Mallard duck (Anas platyrhynchos). Vet Clin Pathol 42/1 (2013) 111–112.
Mass around optic nerve of a dog. Dx? Describe. What are the cell types in each picture?

Dx: Meningioma
(A) The long, rod-shaped, gray structures on the left and upper center are outer segments of photoreceptor rod cells. A few wider, perhaps cone- shaped, cytoplasmic fragments may be present, but outer segments of cone cells were not confidently identified. Nuclei of these photoreceptor cells are bi-lobed with a linear white cleavage between dense chromatin on 2 sides. These small, round nuclei are on the right and bottom and are slightly larger in diameter than an erythrocyte.
(B) Two small clusters of bi-lobed nuclei from the photoreceptor cells are at the upper center and toward the lower right. Several nuclei on the right are damaged, swollen and lack this bi-lobed pattern. The nerve fibers on the lower left were likely from the outer plexi- form layer of the retina.
(C) Nuclei of the outer nuclear layer are in the upper right. Flat, wide polygonal cells from the pigmented epithelial layer are in the left center.
(D) Cells of the pigmented epithelial layer have characteristic pointed oval-shaped melanin granules.
Cytologic appearance of retinal cells included in a fine-needle aspirate of a meningioma around the optic nerve of a dog. Vet Clin Pathol 42/2 (2013) 234–237.
Fine-needle aspirates from cervical lymph node (top) and spleen (bottom) from a dog that whelped stillborn puppies. Dx?

Dx: Disseminated Mycobacterium avium complex infection
What is your diagnosis? Lymph node aspirates from a dog with stillbirth. Vet Clin Pathol 42/3 (2013) 391–392.
Mass around optic nerve of a dog. Dx? Describe.

Dx: Meningioma (The cytologic diagnosis was mesenchymal neoplasia without prominent signs of malignancy)
Meningioma cells had moderate to large amounts of cytoplasm. Variable cell shapes and indistinct “fuzzy” cell borders suggested a mesenchymal cell type. Nuclei displayed mild anisokaryosis, a uniform chromatin pattern and small nucleoli, suggesting a benign tumor. Nuclei were about 1.5–2.5 times an erythrocyte in diameter.
Cytologic appearance of retinal cells included in a fine-needle aspirate of a meningioma around the optic nerve of a dog. Vet Clin Pathol 42/2 (2013) 234–237.